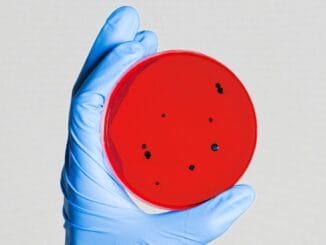

Tümörlerde yaşayan mikroplar kanserin tedavisiyle ilgili ipuçları barındırabilir
Tümörlerin içinde ve çevresinde yaşayan bakteriler ve mantarlar, kanserin nasıl geliştiğini ve nasıl tedavi edilebileceğini anlamada önemli rol oynayabilir. Vücutlarımız farklı canlı türlerini barındırıyor. Bağırsaklar, ağız, burun ve cildimiz hem – DEVAMI …